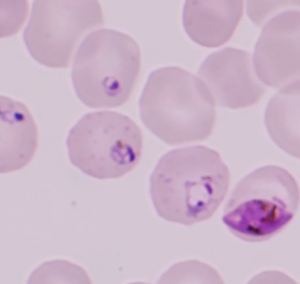
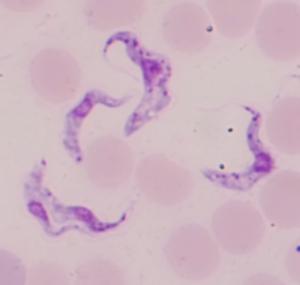

Photo Quiz – Solution
- Trinema sp., Cercozoa, Rhizaria; shelled amoeba; occurrence: mosses and soil.
- Podocyrtis sp., Polycystina, Rhizaria; Radiolaria; occurrence: marine plankton.
- Fragillaria sp., Bacillariophyceae, Stramenopile; colony of diatoms/Bacillariophyceae; occurrence: freshwater plankton.
- Dinophysis sp. (during longitudinal cell division), Dinophyceae, Alveolata; dinoflagellate; occurrence: marine plankton.
- Paramecium sp., Ciliophora, Alveolata; ciliate; occurrence: freshwater.
- Helix pomatia, Gastropoda, Mollusca; snail; occurrence: calcareous substrate in Europe.
- Bosmina sp., Cladocera, Crustacea; water fleas; occurrence: freshwater plankton.
- Calopteryx virgo, Odonata, Insecta; dragonfly; occurrence: in vicinity to streams in Europe, North Africa, and Western Asia.
- Papilio machaon, Lepidoptera, Insecta; butterfly; occurrence: widespread in Europe.
- Esox lucius, Osteichthyes, Vertebrata; fish; occurrence: freshwater of Northern Hemisphere.
- Micronisus gabar, Aves, Vertebrata; bird; occurrence: Africa and Arabia.
- Crocidura russula, Mammalia, Vertebrata; shrew; occurrence: Europe and North Africa.
For introducing students into different topics taught by Assoc.-Prof. Dr. Sabine Agatha, several videos have been produced by the AG Agatha.
Scanning electron microscopy

© 2020 Sabine Agatha All Rights Reserved
Transmission electron microscopy


Transmission electron microscopy
© 2020 Sabine Agatha All Rights Reserved
Paramecium sp. in vivo

This ciliate species (Alveolata, Ciliophora, Oligohymenophorea) is one of the best-known ciliates and frequently used as model organism. The video provides a short introduction into the main cell features. The video was made by means of an Olympus SZX16 stereomicroscope and an Olympus BX53 microscope equipped with differential interference optics and an Olympus camera (OM-D E-M1 Mark II).
© 2020 Sabine Agatha All Rights Reserved
Paramecium sp. – feeding experiment with Congo red stained yeast

Paramecium sp. is a model organism used here for demonstrating phagocytosis, digestion, and exocytosis. Paramecium cells feed yeast stained with the indicator dye congo red. During digestion, the fusion of acidosomes with the digestive vacuoles cause a drop of the pH which is indicated by a colour change from red to blue in the yeast cells. Afterwards, lysomes with enzymes fuse with the digestive vacuoles. Due to the gradual increase of the pH in the digestive vacuoles, the colour of the yeast changes from blue to red. The video was made by means of an Olympus SZX16 stereomicroscope and an Olympus BX53 microscope equipped with differential interference optics and an Olympus camera (OM-D E-M1 Mark II).
© 2020 Sabine Agatha All Rights Reserved
Euplotes daidaleos in vivo and after methyl-green pyronin and Chatton-Lwoff silver nitrate staining

This freshwater euplotid ciliate (Alveolata, Ciliophora, Spirotricha) is characterised by the possession of zoochlorellae. The video provides a short introduction into the main cell features. The video was made by means of an Olympus SZX16 stereomicroscope and an Olympus BX53 microscope equipped with differential interference optics and an Olympus camera (OM-D E-M1 Mark II).
© 2020 Sabine Agatha All Rights Reserved
Stylonychia pustulata in vivo and after methyl-green pyronin staining

The video provides a short introduction into the main cell features of the this freshwater hypotrich ciliate (Alveolata, Ciliophora, Spirotricha). The video was made by means of an Olympus SZX16 stereomicroscope and an Olympus BX53 microscope equipped with differential interference optics and an Olympus camera (OM-D E-M1 Mark II).
© 2020 Sabine Agatha All Rights Reserved
Halteria grandinella in vivo and after methyl-green pyronin staining

The video provides a short introduction into the main cell features of the this freshwater hypotrich ciliate (Alveolata, Ciliophora, Spirotricha). The video was made by means of an Olympus SZX16 stereomicroscope and an Olympus BX53 microscope equipped with differential interference optics and an Olympus camera (OM-D E-M1 Mark II).
© 2020 Sabine Agatha All Rights Reserved
Stentor polymorphus in vivo and after methyl-green pyronin staining

This ciliate species (Alveolata, Ciliophora, Oligohymenophorea) is one of the best-known ciliates and frequently used as model organism. The video provides a short introduction into the main cell features. The video was made by means of an Olympus SZX16 stereomicroscope and an Olympus BX53 microscope equipped with differential interference optics and an Olympus camera (OM-D E-M1 Mark II).
© 2020 Sabine Agatha All Rights Reserved
Helix pomatia (Weinbergschnecke) – Preparation

© 2020 Sabine Agatha All Rights Reserved
Utermöhl chamber

© 2020 Sabine Agatha All Rights Reserved
Analyses of Utermöhl chamber

© 2020 Sabine Agatha All Rights Reserved
Permanent Slides with Testate Amoebae

© 2020 Sabine Agatha All Rights Reserved
Permanent Slides with Radiolaria

Permanent Slides with Radiolaria
© 2020 Sabine Agatha All Rights Reserved
Permanent Slides with Foraminifera

Permanent Slides with Foraminifera
© 2020 Sabine Agatha All Rights Reserved
Life cycle stages of Plasmodium
Life cycle stages of Plasmodium
© 2020 Sabine Agatha All Rights Reserved
Life cycle stages of Trypanosoma
Life cycle stages of Trypanosoma
© 2020 Sabine Agatha All Rights Reserved
„Microscopic Life in Soil“ Unterrichtseinheiten für die 6. Klasse AHS Oberstufe konzipiert von Frau Mag. rer. nat. Susanne Riedl

Protozoen beeinflussen die Bodenfruchtbarkeit und somit die Nahrungsverfügbarkeit für den Menschen, indirekt über den Einfluss auf die Bakterienpopulation, die Hauptzersetzer der Streu, und direkt durch die Abgaben von Stickstoffverbindungen. Im Gegensatz zu Schulbüchern, welche sich üblicherweise auf Metazoen fokussieren und dabei die Protozoen außer Acht lassen, führt die vorliegende Diplomarbeit Unterrichtseinheiten ein, welche sich auf die spezifischen Anpassungen an den ephemeren Charakter des Bodens sowohl der Protozoen als auch der Metazoen konzentrieren und einen vereinfachten Einblick in das Bodennahrungsnetz liefern. Trotz ihrer mikroskopischen Größe sind Protozoen, insbesondere Ciliaten, einfach zu handhaben und liefern genügend morphologische Kennzeichen zur Unterscheidung der Hauptgruppen. Dementsprechend ist es für die Schülerinnen und Schüler möglich, ihre eigenen Hypothesen in den praktischen Einheiten bezüglich der Sukzession, des Nahrungsnetzes, dem Einfluss von Streu und der Wasserverfügbarkeit auf die Abundanz der Protozoen im Boden zu prüfen. Durch die Abdeckung dieser Themen fügen sich die Einheiten nicht nur perfekt in den Lehrplan der österreichischen höheren Schulen, sondern bieten auch die Möglichkeit eines aktiven und anschaulichen Erwerbens von Wissen und Kompetenzen. Mit Ausnahme der Mikroskope sind die Utensilien für die Einheiten kostengünstig und einfach zu beschaffen; die überwiegend angewandte Methode ist die „non-flooded petri dish“ Technik.
© Susanne Riedl